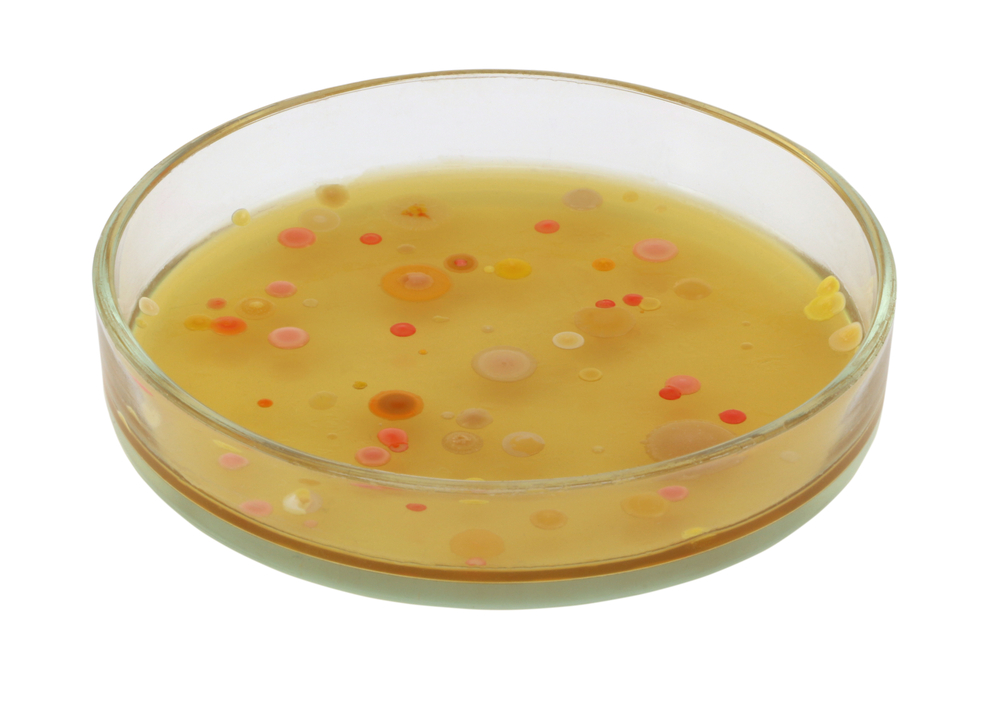

Это заболевание получило самое широкое распространение во время боевых действий. Летальность от газовой гангрены во время Великой Отечественной войны составляла около 60 % потому, что входными воротами этой опасной инфекции являются инфицированные рваные и огнестрельные раны.
Газовая гангрена – хирургическая инфекция, поражающая соединительную и мышечную ткань, которая характеризуется интенсивным течением и стремительным размножением в тканях организма. Размножение микроорганизмов может происходить только в бескислородной среде, т. е. анаэробно, но споры могут долгое время находиться в воздухе.
Травмы и заболевания, при которых возможно развитие газовой гангрены: открытые переломы верхних и нижних конечностей, отрывы конечностей, рвано-ушибленные раны, огнестрельные ранения и травмы в области толстого кишечника, при этом рана должна быть инфицирована, в нее могут попасть загрязненные инородные тела или земля.
Наиболее частые локализации:
- Нижние конечности – 70 %.
- Верхние конечности – 20 %.
- Другие части тела – 10 %.
Возбудитель газовой гангрены

Основной микроорганизм, вызывающий газовую гангрену — Clostridium perfringens (50-60 %). Существуют также другие возбудители газовой гангрены: Cl. novi – 20-50 %; Cl. septicum – 10-15 %; остальные клостридии – 5-6 %.
Клостридии встречаются в окружающей среде очень часто. К тому же они существуют на коже и в кишечнике человека или животных. С выделением каловых масс они попадают в землю, откуда внедряются в поврежденные ткани.
Clostridium perfringens полностью приспособлены жить в бескислородных условиях. Эти микроорганизмы живут в почве, в водоемах, в фекалиях животных. Клостридии очень долго могут сохранять свои свойства в окружающей среде, так как образуют специальную плотную защитную пленку. Они жизнеспособны при воздействии на них высоких и низких температур, ультрафиолетовых лучей и химических веществ.
Факторы риска
Самые благоприятные условия развития газовой гангрены в организме – это недостаток кислорода в ране под повязкой и температура тела человека.
Газовая гангрена может развиваться при наличии некоторых факторов:
- массивные некротизированные ткани в ране;
- нарушения кровоснабжения в конечности, например вследствие наложения жгута;
- серьезные хронические заболевания и сниженный иммунитет;
- сильная кровопотеря;
- травматический шок;
- общее переохлаждение и истощение организма.
Чем больше и обширней поврежденная поверхность, тем выше риск заражения газовой гангреной.
Симптомы
Газовая гангрена быстро распространяется. Инкубационный период, как правило, очень короткий. Иногда он может составлять 3-6 часов, в среднем – 1-2 суток. Существуют также молниеносные формы течения болезни, приводящие к смерти больного уже через 1-2 суток после заражения.
Основные симптомы, по которым можно распознать начало заболевания:
- Ухудшение общего состояния пострадавшего: учащенное сердцебиение, общая слабость, одышка и лихорадка.
- Кожные покровы бледно-серого цвета.
- Появление сильного болевого синдрома в области ранения. Характеризуется жалобами на боль распирающего и давящего характера.
- Быстро нарастающий отек мягких тканей, жалобы на ощущение тесноты в наложенной повязке.
- Нарушение чувствительности пораженной конечности, в дистальных отделах может практически отсутствовать.
- Наличие газа в тканях при активном некрозе тканей. При надавливании на рану выделяются пузырьки газа со специфическим сладковато-гнилостным запахом.
- При надавливании на область раны будет слышен характерный хруст (вследствие скопления газа в отмерших тканях).
- Кожа землистого цвета, вокруг раны бледная, с развитием некроза на ней появляются пятна темного цвета, со временем участки тканей становятся черными и рыхлыми.
- Одной из главных особенностей газовой гангрены является отсутствие в пораженных тканях признаков гнойного воспаления.
В зависимости от преобладающих симптомов различают следующие формы газовой гангрены:
- Отечная – преобладает выраженный отек тканей.
- Эмфизематозная – повышенное газообразование в тканях.
- Смешанная – проявления отечной и эмфизематозной формы.
- Некротическая – преобладает омертвение тканей.
- Флегмонозная – локализация воспаления на ограниченном участке.
- Тканерасплавляющая – стремительное расплавление тканей вследствие некроза с проявлениями общей интоксикации организма.
Диагностика
Диагноз можно поставить, опираясь на клинические проявления заболевания: общую интоксикацию и характерный вид раневой поверхности. Но для подтверждения и оценки тяжести состояния пострадавшего выполняется ряд лабораторных и диагностических анализов:
- общий анализ крови;
- биохимический анализ крови;
- рентгенологическое исследование – определяется «пористость» мышечных тканей;
- микроскопическое исследование:
- бактериоскопия мазков из раны (результат: наличие клостридий на фоне отсутствия лейкоцитов);
- экспресс-биопсия мазков из раны (результат: некроз мышечных волокон);
- метод газовой хроматографии (результат: выявление специфического токсина, циркулирующего в крови).
Лечение
Лечебные мероприятия должны начинаться незамедлительно при первых подозрениях на развитие патологического процесса.
- Выздоровление возможно только при своевременном применении хирургического лечения. При ограниченной и распространенной газовой флегмоне применяется широкое рассечение раны с удалением всех нежизнеспособных тканей, применение трубчатых дренажей для возможности постоянного промывания раны раствором перекиси водорода. Строгая иммобилизация конечности. В стадию гангрены спасти жизнь пациенту возможно только ампутировав зараженную конечность. На первое время швы после операции не накладываются, чтобы к открытой ране был доступ кислорода. Аналогичное дренирование раны.
- Специфическое лечение:
- применение антибиотиков внутривенно или внутримышечно (например, пенициллин 40-60 млн единиц в сутки);
- введение поливалентной противогангренозной сыворотки в количестве 5-6 профилактических доз;
- противогангренозный бактериофаг, вводится внутривенно капельно, медленно.
- Оксибаротерапия.
- Симптоматическая терапия с максимальной детоксикацией организма.
Профилактика
Профилактика возникновения газовой гангрены начинается с устранения всех условий, способствующих ее развитию. Для этого как можно скорее после получения травмы должна быть произведена первичная хирургическая обработка раны. Она включает в себя удаление всех нежизнеспособных тканей и инородных тел, исключается наличие слепых карманов, в которых могут оставаться части некротизированных тканей или инфицированные фрагменты. Накладывается стерильная повязка во избежание повторного загрязнения раны. Строгое соблюдение асептики и антисептики при операциях.
Обязательно рекомендуется профилактическое применение антибиотикотерапии и введение противогангренозной сыворотки в первые часы после получения травмы.
Во время лечения пострадавший должен находиться в отдельной палате, все перевязочные материал (бинты, вата, марля) должны быть как можно скорее утилизированы. Все хирургические инструменты и медицинский инвентарь подвергается многократной дезинфекции. Медицинский персонал (врачи, медсестры и медсестры перевязочного кабинета) после посещения палаты больного должны сменить одежду и обувь на чистую.
К какому врачу обратиться
При подозрении на развитие газовой гангрены необходимо немедленно обратиться в стационар хирургического профиля. Чем раньше будет начато лечение, тем больше шансов сохранить конечность или понизить уровень ее ампутации.
О газовой гангрене в программе «Жить здорово!» с Еленой Малышевой:
